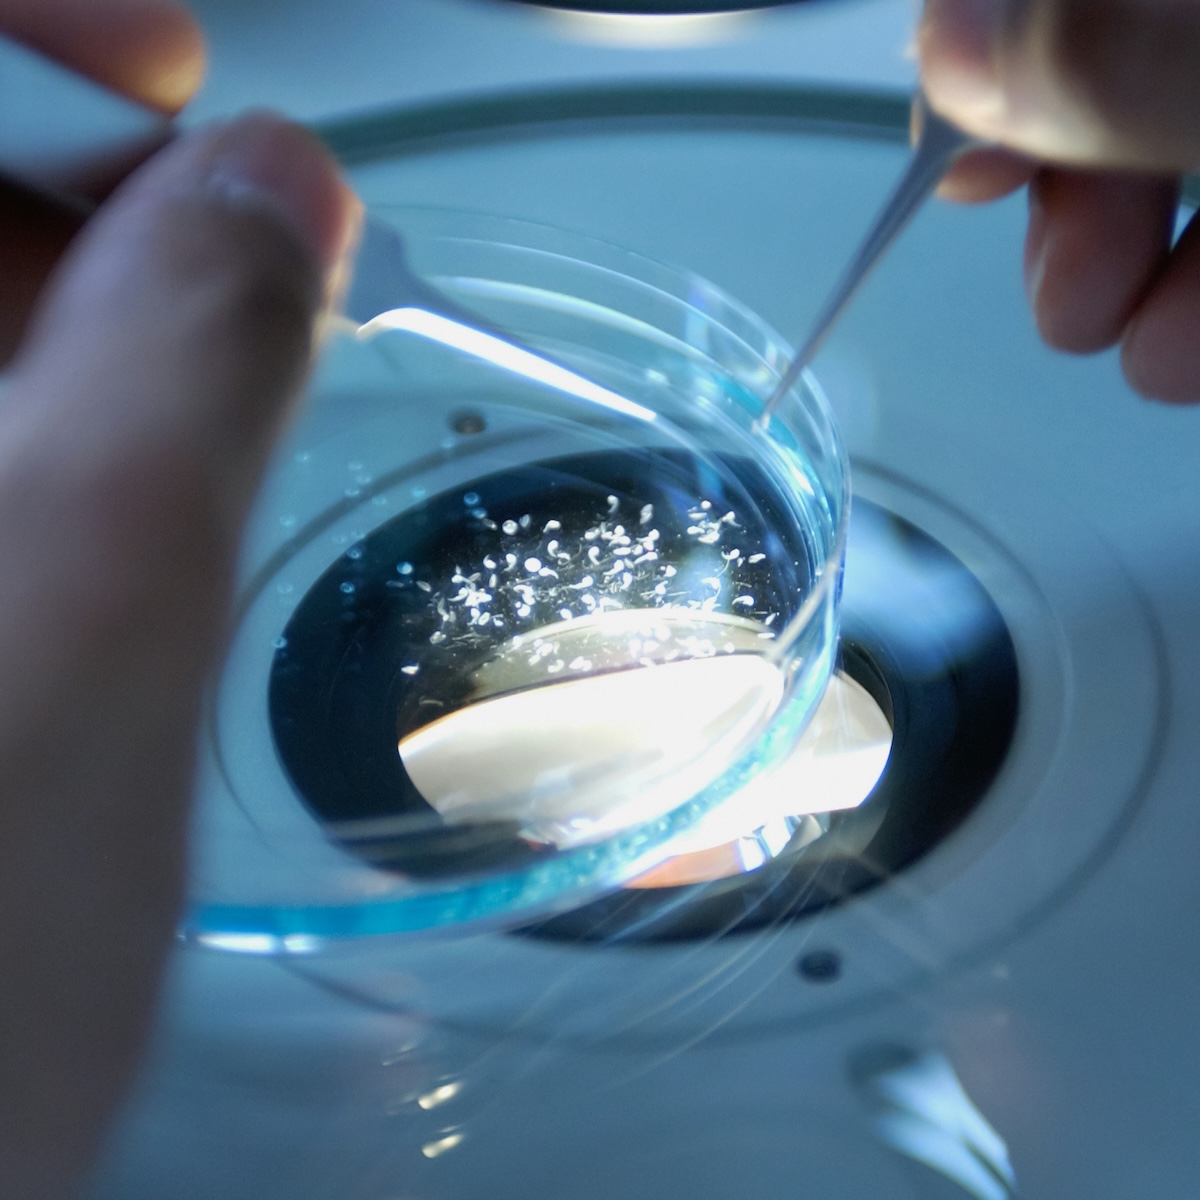

Services
Identifying Potential Partners to Grow Your Business
Shadow Lake Group is a business development advisory firm facilitating strategic business transactions in the life sciences industry. With our extensive networks, we have the ability to quickly identify potential partners or buyers, increasing the chances of an expedited and successful transaction.
Our clients include seed-stage biotech to big pharma in the U.S., Europe, Asia and Canada across a wide range of therapeutic areas. Our highly experienced team of multidisciplinary specialists and global networks deliver a customized process to ensure a favorable outcome for your complex business needs. A successful deal process requires a solid strategy, careful planning and rigorous execution.

Our Experience

Transactions
- $16B+ USD transactions completed by team
- SLG has closed $2.5B+ USD in transactions
- Clients include seed-stage biotech to big pharma
- Global transactional experience
Science
- Team with solid life sciences credentials
- Global industry experience
- Wide range of therapeutic areas
- Access to various therapeutic area experts

Business
- Successful entrepreneur exits
- 80+ years experience in corporate growth strategies
- Extensive global networks
- Expert company and product financial modeling / valuation

Transactional

Strategic Consulting

Financial Valuation
Shadow Lake Group is well-positioned to navigate through every step of complex transactions to deliver customized strategic advisory services. Take a look at our completed transactions and case studies.
Collaborate with Us!
Shadow Lake Group is well positioned to navigate through every step of a complex transaction to deliver customized strategic advisory services.
